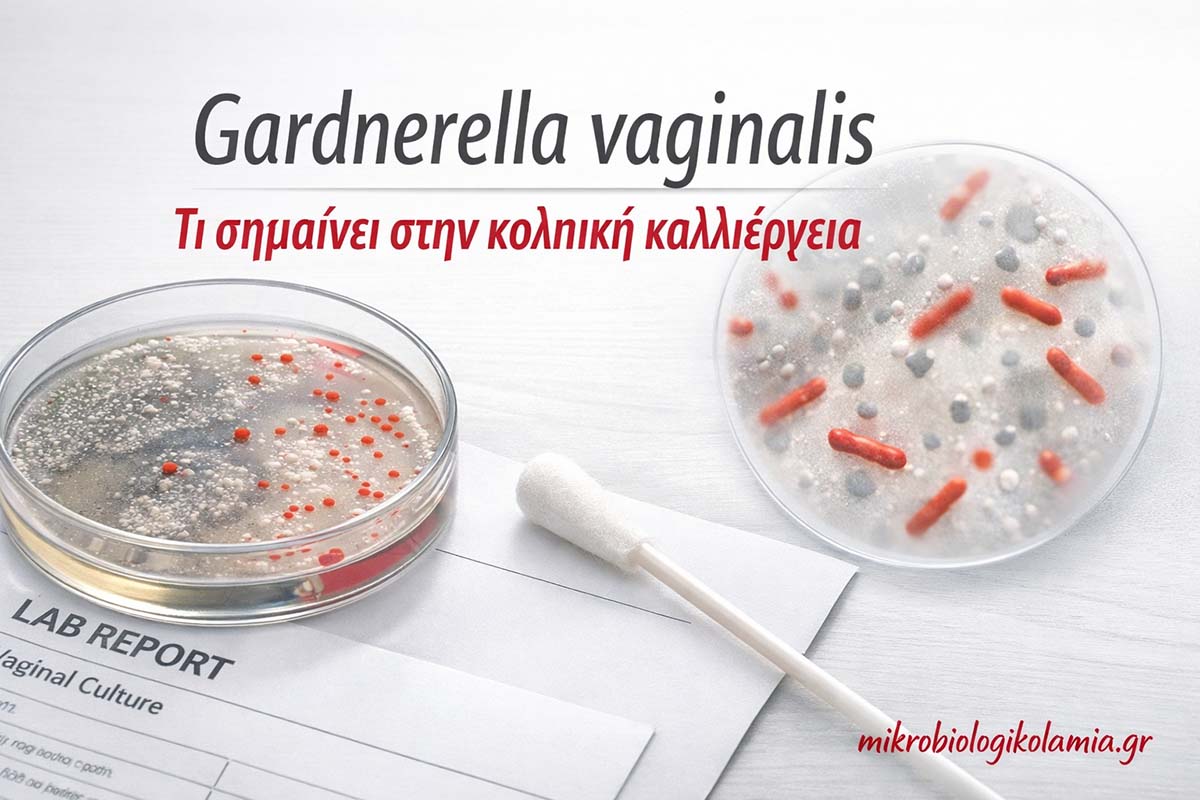

Gardnerella vaginalis: τι δείχνει στην κολπική καλλιέργεια και πώς ερμηνεύεται
Gardnerella vaginalis στην κολπική καλλιέργεια: τι σημαίνει, πότε χρειάζεται θεραπεία και πώς ερμηνεύεται σωστά
Τελευταία ενημέρωση:
Σύντομη περίληψη:
Η ανεύρεση Gardnerella vaginalis σε κολπική καλλιέργεια δεν σημαίνει πάντα αυτόματα ότι υπάρχει «σοβαρή λοίμωξη» που χρειάζεται άμεσα θεραπεία. Πολύ συχνά συνδέεται με βακτηριακή κολπίτιδα / βακτηριακή κολπίδωση, δηλαδή με διαταραχή της φυσιολογικής κολπικής χλωρίδας.
Στην πράξη, δεν αρκεί μόνο το όνομα του μικροβίου στο αποτέλεσμα. Η σωστή ερμηνεία βασίζεται στα συμπτώματα, στο κολπικό pH, στη μικροσκόπηση, στα συνοδά ευρήματα και στη συνολική γυναικολογική εικόνα.
Ο όρος «αιμόφιλος» μπορεί να μπερδέψει, γιατί σε παλαιότερη ορολογία συνδέθηκε ιστορικά με το Gardnerella vaginalis. Για αυτό η πραγματική αξία δεν είναι απλώς «τι γράφει το χαρτί», αλλά πώς διαβάζεται σωστά.
1
Τι σημαίνει όταν η κολπική καλλιέργεια γράφει Gardnerella vaginalis
Όταν μια γυναίκα διαβάζει στο αποτέλεσμα της κολπικής καλλιέργειας το όνομα Gardnerella vaginalis, το πρώτο συναίσθημα είναι συνήθως ανησυχία. Η σκέψη «βρέθηκε μικρόβιο» οδηγεί εύκολα στο συμπέρασμα ότι υπάρχει οπωσδήποτε λοίμωξη που χρειάζεται φάρμακα, ίσως ότι πρόκειται για κάτι μεταδιδόμενο ή ότι η κατάσταση είναι πιο σοβαρή απ’ όσο πραγματικά είναι. Στην πράξη όμως, η ερμηνεία του συγκεκριμένου ευρήματος δεν είναι τόσο απλή.
Το Gardnerella συνδέεται στενά με τη βακτηριακή κολπίτιδα, αλλά η βακτηριακή κολπίτιδα δεν είναι απλώς «μόλυνση από ένα μικρόβιο». Είναι κυρίως διαταραχή του φυσιολογικού κολπικού μικροβιώματος. Αυτό σημαίνει ότι η παρουσία του Gardnerella σε μια καλλιέργεια μπορεί να αποκτά πολύ διαφορετική σημασία ανάλογα με το αν υπάρχουν συμπτώματα, αν το pH είναι αυξημένο, αν υπάρχουν clue cells στη μικροσκόπηση, αν υπάρχουν υποτροπές, αν η γυναίκα είναι έγκυος και αν συνυπάρχουν άλλα ευρήματα.
Με απλά λόγια, άλλο πράγμα είναι ένα χαρτί που γράφει Gardnerella και άλλο πράγμα η κλινική διάγνωση ότι η γυναίκα έχει ενεργό, συμπτωματική βακτηριακή κολπίτιδα. Ένα θετικό αποτέλεσμα δεν πρέπει να οδηγεί ούτε σε αδιαφορία ούτε σε υπερβολικό πανικό. Πρέπει να οδηγεί σε σωστή ερμηνεία. Και αυτή η ερμηνεία βασίζεται πάντα στο σύνολο των δεδομένων.
Γι’ αυτό ο σωστός τρόπος να διαβαστεί το αποτέλεσμα δεν είναι «βρέθηκε μικρόβιο, άρα έχω συγκεκριμένη λοίμωξη». Είναι «βρέθηκε μικροβιακό εύρημα που μπορεί να σχετίζεται με βακτηριακή κολπίτιδα και πρέπει να εκτιμηθεί μαζί με την υπόλοιπη εικόνα». Αυτό το σημείο είναι το κεντρικό μήνυμα ολόκληρου του άρθρου.
2
Τι είναι το Gardnerella vaginalis
Το Gardnerella vaginalis είναι βακτηριακός μικροοργανισμός που έχει συνδεθεί ιστορικά με τη βακτηριακή κολπίτιδα. Σήμερα όμως γνωρίζουμε ότι η κατάσταση αυτή δεν εξηγείται πάντα μόνο από την παρουσία ενός βακτηρίου. Η βακτηριακή κολπίτιδα είναι κυρίως μια πολυμικροβιακή δυσβίωση. Δηλαδή, αλλάζει το ισοζύγιο ανάμεσα στους φυσιολογικούς προστατευτικούς λακτοβακίλλους και σε άλλα βακτήρια που ευνοούνται όταν το κολπικό περιβάλλον παύει να είναι τόσο όξινο και σταθερό όσο θα έπρεπε.
Στον φυσιολογικό κόλπο, οι Lactobacillus κυριαρχούν και βοηθούν στη διατήρηση χαμηλού pH. Αυτό το περιβάλλον λειτουργεί προστατευτικά. Όταν για διάφορους λόγους η ισορροπία αυτή διαταραχθεί, μειώνονται οι λακτοβάκιλλοι και αυξάνεται η ανάπτυξη άλλων μικροοργανισμών. Το Gardnerella είναι από τους πιο γνωστούς από αυτούς, αλλά δεν είναι ο μόνος. Συχνά συνυπάρχουν και άλλα αναερόβια ή σχετιζόμενα βακτήρια, τα οποία μαζί συνθέτουν την εικόνα της βακτηριακής κολπίτιδας.
Αυτό έχει πρακτική σημασία γιατί εξηγεί γιατί το Gardnerella μπορεί να ανιχνεύεται χωρίς πάντα να σημαίνει το ίδιο πράγμα. Σε μία γυναίκα σημαίνει ενεργή, συμπτωματική BV. Σε άλλη μπορεί να σημαίνει ηπιότερη δυσβίωση, ενώ σε άλλη ένα εργαστηριακό εύρημα που από μόνο του δεν αρκεί να εξηγήσει τα συμπτώματα. Άρα, δεν αρκεί να ξέρουμε «ποιο είναι το βακτήριο». Πρέπει να ξέρουμε σε ποιο περιβάλλον βρέθηκε.
Ένα ακόμη σημείο με ιδιαίτερη αξία είναι ότι το Gardnerella μπορεί να συμμετέχει σε σχηματισμό βιοφίλμ, δηλαδή μικροβιακής δομής που προσκολλάται στο επιθήλιο και ευνοεί την επιμονή ή την επανεμφάνιση της δυσβίωσης. Αυτό βοηθά να καταλάβουμε γιατί αρκετές γυναίκες έχουν υποτροπές, ακόμη και όταν η αρχική αγωγή φάνηκε να βοηθά.
3
Τι σημαίνει ο όρος «αιμόφιλος» στην καλλιέργεια
Ο όρος «αιμόφιλος» προκαλεί συχνά αναστάτωση, επειδή ακούγεται σαν κάτι εντελώς διαφορετικό ή ίσως πιο «βαρύ» από το Gardnerella. Στο γυναικολογικό και μικροβιολογικό πλαίσιο, όμως, υπάρχει σημαντικό ιστορικό υπόβαθρο πίσω από αυτή τη λέξη. Το Gardnerella vaginalis είχε παλαιότερα συσχετιστεί ονοματολογικά με τον όρο Haemophilus vaginalis, γι’ αυτό σε παλαιότερες περιγραφές ή ακόμη και σε ορισμένες συνήθειες καθημερινής αναφοράς μπορεί να συναντηθεί η λέξη «αιμόφιλος».
Αυτό δεν σημαίνει ότι κάθε φορά η χρήση του όρου είναι απόλυτα ακριβής ή σύγχρονη. Σημαίνει όμως ότι πολύ συχνά, όταν μια γυναίκα ακούει «βγήκε αιμόφιλος», στην ουσία γίνεται αναφορά σε μικροβιακό εύρημα που σχετίζεται με το ίδιο εννοιολογικό πλαίσιο του Gardnerella vaginalis. Για αυτό δεν πρέπει να θεωρεί αυτομάτως ότι πρόκειται για ένα δεύτερο, εντελώς διαφορετικό και ανεξάρτητο παθογόνο που βρέθηκε επιπλέον.
Η καλύτερη πρακτική, όταν υπάρχει ασαφής ή παλιότερη διατύπωση, είναι να ζητείται ακριβής διευκρίνιση από το εργαστήριο ή τον γιατρό. Αν το αποτέλεσμα γράφει καθαρά Gardnerella vaginalis, δεν υπάρχει πρόβλημα ερμηνείας. Αν όμως γίνεται λόγος για «αιμόφιλο» σε προφορική ενημέρωση ή σε παλαιότερο ιστορικό, καλό είναι να ξεκαθαρίζεται ακριβώς τι εννοείται.
Συνεπώς, η γυναίκα δεν πρέπει να πανικοβάλλεται από τη λέξη. Το κρίσιμο ερώτημα παραμένει το ίδιο: υπάρχει κλινική εικόνα που ταιριάζει με βακτηριακή κολπίτιδα ή όχι; Η ονοματολογία έχει τη σημασία της, αλλά η ουσία είναι πάντα η κλινική ερμηνεία.
Σε πολλές παλαιότερες αναφορές, ο όρος «αιμόφιλος» συνδέεται ιστορικά με το Gardnerella vaginalis και δεν περιγράφει απαραίτητα άλλο, ανεξάρτητο μικρόβιο.
4
Τι είναι η κολπική καλλιέργεια και τι ακριβώς εξετάζει
Η κολπική καλλιέργεια είναι εξέταση μικροβιολογικού ελέγχου κατά την οποία λαμβάνεται δείγμα από τον κόλπο με ειδικό στυλεό και το υλικό τοποθετείται σε κατάλληλα θρεπτικά μέσα, ώστε να φανεί αν αναπτύσσονται συγκεκριμένοι μικροοργανισμοί. Ανάλογα με τη μεθοδολογία του εργαστηρίου και το ερώτημα του γιατρού, μπορεί να αναζητηθούν βακτήρια, ζυμομύκητες και άλλα μικροβιακά ευρήματα που σχετίζονται με κολπικά ενοχλήματα ή φλεγμονή.
Αυτό που πρέπει να γίνει ξεκάθαρο είναι ότι η καλλιέργεια δεν είναι το ίδιο πράγμα με την άμεση μικροσκόπηση ή με τη συνολική εκτίμηση του κολπικού μικροβιώματος. Η καλλιέργεια απαντά κυρίως στο ερώτημα «τι μπορεί να αναπτυχθεί από το δείγμα που ελήφθη». Δεν απαντά πάντοτε μόνη της στο ερώτημα «ποιο είναι το πραγματικό αίτιο των συμπτωμάτων». Αυτό είναι ιδιαίτερα σημαντικό στη βακτηριακή κολπίτιδα, γιατί εκεί το πρόβλημα είναι συνήθως συνολική μεταβολή της χλωρίδας και όχι απλώς η απομόνωση ενός συγκεκριμένου μικροβίου.
Έτσι, η κολπική καλλιέργεια είναι πολύτιμη, αλλά πρέπει να εντάσσεται στο σωστό διαγνωστικό πλαίσιο. Σε γυναίκα με υποτροπές, με αποτυχία προηγούμενης θεραπείας, με μικτή εικόνα ή με αμφιβολία στη διαφορική διάγνωση, η καλλιέργεια μπορεί να δώσει πολύ χρήσιμες πληροφορίες. Σε άλλες περιπτώσεις, η κλινική εξέταση, το pH, η μικροσκόπηση, το whiff test ή ακόμη και νεότερες μοριακές μέθοδοι έχουν μεγαλύτερη αξία.
Για αυτό, όταν μια ασθενής ρωτά «η καλλιέργεια θα μου πει ακριβώς τι έχω;», η πιο σωστή απάντηση είναι: θα βοηθήσει πολύ, αλλά δεν είναι πάντα το μοναδικό ή το τελικό κομμάτι της διάγνωσης.
5
Πότε ζητείται κολπική καλλιέργεια
Η κολπική καλλιέργεια ζητείται συχνά όταν μια γυναίκα έχει αυξημένα υγρά, δυσάρεστη οσμή, κνησμό, κάψιμο, αίσθημα ερεθισμού ή επαναλαμβανόμενες ενοχλήσεις που δεν εξηγούνται εύκολα. Είναι επίσης πολύ χρήσιμη όταν τα συμπτώματα παραμένουν παρά τη θεραπεία, όταν η διάγνωση δεν είναι σαφής ή όταν υπάρχει υποψία ότι συνυπάρχουν περισσότερες από μία αιτίες, όπως για παράδειγμα Gardnerella και Candida ή άλλη μικτή κολπίτιδα.
Σε αρκετές γυναίκες ζητείται επειδή υπάρχουν υποτροπές. Δηλαδή, η ασθενής παίρνει θεραπεία, βελτιώνεται και μετά από μικρό διάστημα τα συμπτώματα ξαναεμφανίζονται. Σε αυτήν την περίπτωση η καλλιέργεια βοηθά να χαρτογραφηθεί πιο σωστά το μικροβιακό περιβάλλον και να αποκλειστεί άλλη ή συνυπάρχουσα αιτία. Μπορεί επίσης να ζητηθεί στην κύηση όταν υπάρχουν συμπτώματα ή σε γυναικολογικά πλαίσια όπου χρειάζεται πιο προσεκτική εργαστηριακή εκτίμηση.
Δεν σημαίνει όμως ότι κάθε ήπια, παροδική ενόχληση χρειάζεται πάντα καλλιέργεια. Υπάρχουν περιστατικά όπου η κλινική εικόνα είναι τόσο τυπική, ώστε ο γυναικολόγος μπορεί να κινηθεί διαφορετικά. Η μεγάλη αξία της καλλιέργειας είναι όταν η εικόνα είναι αμφίβολη, επίμονη, υποτροπιάζουσα ή μικτή.
Με απλά λόγια, η κολπική καλλιέργεια δεν είναι «τυπική γραφειοκρατική εξέταση». Είναι στοχευμένο εργαλείο, ιδίως όταν ο γιατρός χρειάζεται καλύτερη εικόνα του τι πραγματικά συμβαίνει.
6
Gardnerella και βακτηριακή κολπίτιδα: ποια είναι η σχέση τους
Η σχέση ανάμεσα στο Gardnerella vaginalis και στη βακτηριακή κολπίτιδα είναι πολύ στενή, αλλά δεν είναι απόλυτα ταυτόσημη. Η βακτηριακή κολπίτιδα είναι η κλινική και εργαστηριακή οντότητα. Το Gardnerella είναι ένας από τους κύριους μικροοργανισμούς που σχετίζονται με αυτήν. Αυτό σημαίνει ότι μπορεί να υπάρχει βακτηριακή κολπίτιδα όπου το Gardnerella έχει σημαντικό ρόλο, αλλά η ίδια η νόσος δεν ταυτίζεται απλώς με την παρουσία του συγκεκριμένου βακτηρίου.
Η βακτηριακή κολπίτιδα είναι κατά βάση μεταβολή της οικολογίας του κόλπου. Οι φυσιολογικοί λακτοβάκιλλοι, που κρατούν το περιβάλλον όξινο και προστατευμένο, μειώνονται. Το pH ανεβαίνει, αλλάζει η σύσταση των εκκρίσεων και ευνοείται η ανάπτυξη άλλων μικροβίων. Το Gardnerella συχνά βρίσκεται στο επίκεντρο αυτής της μεταβολής, αλλά συνήθως δεν δρα μόνο του. Γι’ αυτό και η διάγνωση απαιτεί αξιολόγηση της συνολικής εικόνας και όχι μόνο αν βρέθηκε ένα όνομα στην καλλιέργεια.
Η πρακτική σημασία αυτής της διάκρισης είναι τεράστια. Αν διαβάσουμε το αποτέλεσμα επιφανειακά, μπορεί να πούμε «βρέθηκε Gardnerella, άρα έχω βακτηριακή κολπίτιδα». Αν όμως το διαβάσουμε ιατρικά, λέμε «βρέθηκε Gardnerella, που συχνά συνδέεται με βακτηριακή κολπίτιδα, αλλά πρέπει να δω αν υπάρχουν τα υπόλοιπα στοιχεία που ολοκληρώνουν τη διάγνωση».
Αυτή η πιο ώριμη ερμηνεία προστατεύει τόσο από την υπερθεραπεία όσο και από την υποεκτίμηση. Ειδικά στο θέμα της κολπικής καλλιέργειας, αυτό είναι από τα πιο σημαντικά σημεία που πρέπει να καταλάβει η γυναίκα.
7
Ποια συμπτώματα ταιριάζουν περισσότερο με Gardnerella / BV
Το πιο χαρακτηριστικό σύμπτωμα που οδηγεί στη σκέψη για βακτηριακή κολπίτιδα είναι η δυσάρεστη οσμή, συχνά περιγραφόμενη ως «ψαρίλα». Η οσμή αυτή μπορεί να είναι διαρκής ή να γίνεται πιο έντονη μετά από σεξουαλική επαφή ή γύρω από την περίοδο. Πολλές γυναίκες περιγράφουν επίσης αυξημένα, πιο υδαρή ή λεπτόρρευστα γκριζόλευκα υγρά, χωρίς απαραίτητα να υπάρχει πολύ έντονος κνησμός.
Αυτό είναι σημαντικό, γιατί διαχωρίζει σε κάποιο βαθμό τη βακτηριακή κολπίτιδα από τη μυκητίαση. Στη Candida, ο κνησμός είναι συχνά πιο έντονος, υπάρχει περισσότερο εξωτερικός ερεθισμός, ενώ το έκκριμα είναι συνήθως πιο πηχτό και λευκό. Στη βακτηριακή κολπίτιδα το κεντρικό σύμπτωμα είναι συνήθως η οσμή και η αλλαγή της φύσης των υγρών, όχι τόσο η έντονη φαγούρα.
Μπορεί επίσης να υπάρχει ήπιο κάψιμο, αίσθημα ενόχλησης ή δυσφορία, αλλά η εικόνα συχνά είναι πιο «χημική» και λιγότερο έντονα φλεγμονώδης από άλλες κολπίτιδες. Παρ’ όλα αυτά, υπάρχουν και ασυμπτωματικές γυναίκες. Αυτός είναι ένας ακόμη λόγος που το αποτέλεσμα της καλλιέργειας δεν πρέπει να αποκόπτεται από το αν πράγματι η γυναίκα έχει παράπονα.
Είναι επίσης σημαντικό ότι τα συμπτώματα δεν είναι πάντα εντελώς «καθαρά». Μια γυναίκα μπορεί να έχει και οσμή και κνησμό, ιδίως αν συνυπάρχει και μυκητίαση ή άλλη αιτία. Γι’ αυτό η συμπτωματολογία είναι πολύ χρήσιμη, αλλά δεν αντικαθιστά ούτε τη μικροσκόπηση ούτε τη συνολική γυναικολογική αξιολόγηση.
8
Γιατί η κολπική καλλιέργεια δεν αρκεί πάντα για διάγνωση
Αυτό είναι ίσως το πιο ουσιαστικό ιατρικό σημείο του άρθρου. Η κολπική καλλιέργεια είναι χρήσιμη, αλλά στην περίπτωση της βακτηριακής κολπίτιδας έχει όρια. Η απλή ανάπτυξη ή απομόνωση του Gardnerella vaginalis δεν είναι ειδική διάγνωση από μόνη της. Δηλαδή, το ίδιο μικρόβιο μπορεί να ανιχνευθεί σε γυναίκες με σαφή συμπτωματική BV, αλλά μπορεί να βρεθεί και σε γυναίκες χωρίς τυπική ενεργό εικόνα.
Αυτό συμβαίνει επειδή η βακτηριακή κολπίτιδα είναι κυρίως διαταραχή ισορροπίας της χλωρίδας και όχι μόνο παρουσία ενός «εισβολέα». Επομένως, το ζητούμενο δεν είναι απλώς να μάθουμε αν υπάρχει Gardnerella, αλλά να δούμε πώς είναι συνολικά το κολπικό περιβάλλον. Ποιο είναι το pH; Υπάρχουν clue cells; Υπάρχει θετικό whiff test; Η μικροσκόπηση δείχνει συμβατή εικόνα; Υπάρχουν μειωμένοι λακτοβάκιλλοι; Υπάρχουν λευκοκύτταρα ή άλλα ευρήματα που στρέφουν αλλού τη διάγνωση;
Αυτό δεν μειώνει την αξία της καλλιέργειας. Αντίθετα, την τοποθετεί στη σωστή θέση. Η καλλιέργεια είναι πολύ χρήσιμη όταν ενσωματώνεται σε ευρύτερη διαγνωστική σκέψη. Δεν είναι όμως πάντα το «καλύτερο τεστ» για να πει με απόλυτη βεβαιότητα αν μια γυναίκα έχει ή όχι βακτηριακή κολπίτιδα.
Με απλά λόγια, αν μια γυναίκα ρωτήσει «έχω Gardnerella στην καλλιέργεια, άρα έχω BV;», η πιο έντιμη απάντηση είναι: πιθανόν, αλλά όχι μόνο από αυτό το εύρημα. Χρειάζεται συσχέτιση με συμπτώματα, pH, μικροσκόπηση και συνολική κλινική εικόνα.
9
Τι ρόλο έχουν pH, whiff test, clue cells και Nugent score
Η πιο αξιόπιστη κλασική προσέγγιση στη διάγνωση της βακτηριακής κολπίτιδας βασίζεται στα κριτήρια Amsel και στη μικροσκοπική/Gram αξιολόγηση τύπου Nugent. Το κολπικό pH στη BV είναι συνήθως πάνω από 4,5. Το whiff test ανιχνεύει τη χαρακτηριστική οσμή αμινών μετά από προσθήκη KOH. Τα clue cells είναι επιθηλιακά κύτταρα καλυμμένα από βακτήρια, εύρημα ιδιαίτερα ενδεικτικό.
Το Nugent score βασίζεται σε χρώση Gram και αξιολογεί πόσο κυριαρχούν οι λακτοβάκιλλοι και πόσο έχουν αυξηθεί τα μικρόβια που σχετίζονται με BV. Με αυτόν τον τρόπο αποτυπώνει πολύ πιο ρεαλιστικά τη βιολογική ουσία του προβλήματος: όχι απλώς το αν υπάρχει ένα βακτήριο, αλλά το αν έχει αλλάξει η ισορροπία του μικροβιώματος.
Αυτό είναι το μεγάλο πλεονέκτημα της μικροσκόπησης και της σωστής εργαστηριακής αξιολόγησης της χλωρίδας. Εξηγεί γιατί σε μια γυναίκα με δύσοσμα υγρά και αυξημένο pH, το Gardnerella έχει άλλη βαρύτητα απ’ ό,τι σε μια γυναίκα χωρίς συμπτώματα, φυσιολογικό pH και μη συμβατή μικροσκοπική εικόνα.
Στη σύγχρονη πράξη υπάρχουν και μοριακές μέθοδοι, οι οποίες μπορεί να βοηθήσουν ακόμη περισσότερο, ιδιαίτερα σε συμπτωματικές γυναίκες ή σε περιπτώσεις που δεν υπάρχει εύκολη άμεση μικροσκοπική αξιολόγηση. Παρ’ όλα αυτά, ακόμη και τότε, η κλινική συσχέτιση παραμένει απαραίτητη.
10
Πώς διαβάζεται σωστά ένα αποτέλεσμα κολπικής καλλιέργειας
Η σωστή ανάγνωση μιας κολπικής καλλιέργειας δεν είναι απλή ανάγνωση ονομάτων. Χρειάζεται να απαντηθούν τέσσερα βασικά ερωτήματα: ποιο μικρόβιο βρέθηκε, αν ταιριάζει με τα συμπτώματα, αν συνοδεύεται από άλλα ευρήματα και τι έδειξε η υπόλοιπη κλινική αξιολόγηση. Χωρίς αυτά, το αποτέλεσμα μπορεί εύκολα να παρερμηνευθεί.
Αν για παράδειγμα το αποτέλεσμα αναφέρει Gardnerella και η γυναίκα έχει κλασική ψαρίλα, λεπτόρρευστα γκριζόλευκα υγρά και αυξημένο pH, τότε η κλινική υποψία για βακτηριακή κολπίτιδα είναι ισχυρή. Αν όμως το αποτέλεσμα γράφει Gardnerella αλλά η γυναίκα δεν έχει συμπτώματα ή έχει κυρίως έντονο κνησμό και τυρώδες έκκριμα, τότε η ερμηνεία δεν είναι το ίδιο απλή. Εκεί μπορεί να χρειάζεται πιο προσεκτική διαφοροδιάγνωση.
Ακόμη πιο σημαντικό είναι να δούμε αν υπάρχουν αναφορές για λευκοκύτταρα, μύκητες, μικτή χλωρίδα ή άλλα σχόλια. Η βακτηριακή κολπίτιδα συνήθως δεν είναι η πιο έντονα φλεγμονώδης εικόνα. Αν υπάρχουν πολλά λευκοκύτταρα ή άλλα σημεία φλεγμονής, μπορεί να συνυπάρχει κάτι διαφορετικό ή κάτι επιπλέον.
| Εργαστηριακό / κλινικό εύρημα | Πιο πιθανή ανάγνωση | Τι χρειάζεται επιπλέον |
|---|---|---|
| Gardnerella + οσμή + λεπτόρρευστο γκριζόλευκο έκκριμα | Ισχυρά συμβατό με βακτηριακή κολπίτιδα | pH, μικροσκόπηση, συνολική κλινική συσχέτιση |
| Gardnerella χωρίς συμπτώματα | Ασυμπτωματική δυσβίωση ή εύρημα περιορισμένης σημασίας | Ιστορικό, κύηση, επανεκτίμηση αν χρειάζεται |
| Candida + έντονος κνησμός | Πιο συμβατό με μυκητίαση | Έλεγχος αν συνυπάρχει άλλη αιτία |
| Πολλά λευκοκύτταρα / έντονη φλεγμονώδης εικόνα | Πιθανή άλλη ή μικτή λοίμωξη | Περαιτέρω γυναικολογική και μικροβιολογική εκτίμηση |
| Μικτή χλωρίδα / ασαφής αναφορά | Δυσβίωση ή μικτή αιτιολογία | Συσχέτιση με συμπτώματα και μικροσκόπηση |
Το βασικό μήνυμα εδώ είναι ότι το αποτέλεσμα της καλλιέργειας πρέπει να διαβάζεται όπως διαβάζουμε ένα κομμάτι παζλ. Μόνο του λέει κάτι. Μαζί με τα υπόλοιπα λέει πολύ περισσότερα.
11
Τι σημαίνει θετικό αποτέλεσμα χωρίς συμπτώματα
Η θετική ανεύρεση Gardnerella vaginalis χωρίς εμφανή συμπτώματα είναι από τα πιο συχνά σενάρια που προκαλούν άγχος. Πολλές γυναίκες ρωτούν: «Βγήκε μικρόβιο, αλλά εγώ δεν έχω οσμή, δεν έχω υγρά, δεν έχω κάτι ιδιαίτερο. Πρέπει να ανησυχώ;». Στις περισσότερες περιπτώσεις, η απάντηση είναι ότι δεν χρειάζεται πανικός, αλλά χρειάζεται σωστή ιατρική ερμηνεία.
Ένα θετικό εύρημα χωρίς συμπτώματα μπορεί να σημαίνει ασυμπτωματική δυσβίωση, μικροβιακή μετατόπιση ή εύρημα που αποκτά σημασία μόνο σε ειδικό κλινικό πλαίσιο. Δεν είναι υποχρεωτικά το ίδιο με ενεργή, ενοχλητική βακτηριακή κολπίτιδα. Για αυτό δεν είναι σωστό να ξεκινά πάντα θεραπεία μόνο και μόνο επειδή υπάρχει μια θετική λέξη στο χαρτί.
Η άσκοπη θεραπεία μπορεί να έχει μειονεκτήματα. Μπορεί να διαταράξει ακόμη περισσότερο το κολπικό μικροβίωμα, να προκαλέσει μυκητίαση μετά από αντιβιοτικά ή να δημιουργήσει κύκλο συνεχούς ανησυχίας και επαναλαμβανόμενων παρεμβάσεων χωρίς πραγματικό όφελος. Από την άλλη, σε ειδικές καταστάσεις όπως η εγκυμοσύνη ή σε γυναίκες με πολύ ειδικό ιστορικό, η ερμηνεία γίνεται πιο προσεκτικά.
Άρα, το «θετικό χωρίς συμπτώματα» δεν ισοδυναμεί αυτόματα με «αδιαφορώ», αλλά ούτε και με «θεραπεύομαι οπωσδήποτε». Σημαίνει ότι η τελική απόφαση πρέπει να προκύψει από το σύνολο του ιστορικού και από τη γνώμη του γιατρού.
12
Gardnerella, Candida, Trichomonas και άλλες αιτίες κολπικών ενοχλημάτων
Δεν είναι όλα τα κολπικά ενοχλήματα ίδια και δεν σημαίνει κάθε έκκριμα το ίδιο πράγμα. Η σωστή διαφοροδιάγνωση είναι πολύ σημαντική γιατί πολλές γυναίκες αντιμετωπίζουν τα πάντα σαν «μύκητες» ή σαν «μικρόβιο» χωρίς να ξεχωρίζουν τι πραγματικά συμβαίνει. Στην πράξη, τα πιο συχνά σενάρια είναι η βακτηριακή κολπίτιδα, η μυκητίαση, η τριχομονάδα και άλλες φλεγμονώδεις ή μικτές καταστάσεις.
Η Candida συνήθως δίνει πιο έντονο κνησμό, περισσότερο κάψιμο, εξωτερικό ερεθισμό και παχύτερο λευκό έκκριμα. Η Trichomonas μπορεί να δώσει πιο έντονη ενόχληση, καύσο, οσμή και συχνά αφρώδες κιτρινοπράσινο έκκριμα. Η βακτηριακή κολπίτιδα τείνει να δίνει πιο λεπτόρρευστο γκριζόλευκο έκκριμα και χαρακτηριστική ψαρίλα, με λιγότερο έντονο κνησμό σε σχέση με τους μύκητες.
Υπάρχουν και μικτές καταστάσεις. Για παράδειγμα, μια γυναίκα μπορεί να έχει ταυτόχρονα δυσβίωση τύπου BV και μυκητίαση, οπότε η εικόνα γίνεται πιο μπερδεμένη. Εκεί, η καλλιέργεια και η μικροσκόπηση έχουν μεγάλη αξία, γιατί η αυτοδιάγνωση συνήθως αποτυγχάνει.
| Κατάσταση | Συχνά συμπτώματα | Χαρακτήρας εκκρίσεων | Στοιχείο που ξεχωρίζει |
|---|---|---|---|
| Gardnerella / BV | Οσμή, αυξημένα υγρά, ήπια ενόχληση | Λεπτόρρευστο, γκριζόλευκο | Ψαρίλα, pH > 4,5, clue cells |
| Candida | Έντονος κνησμός, εξωτερικός ερεθισμός, κάψιμο | Πηχτό, λευκό, «τυρώδες» | Πιο έντονη φαγούρα και ερυθρότητα |
| Trichomonas | Καύσος, ερεθισμός, οσμή | Αφρώδες, κιτρινοπράσινο | Σεξουαλικώς μεταδιδόμενη λοίμωξη |
| Άλλη φλεγμονώδης / αερόβια κολπίτιδα | Πόνος, καύσος, πιο έντονη φλεγμονή | Ποικίλλει | Συχνά περισσότερα λευκοκύτταρα και πιο φλεγμονώδης εικόνα |
Αυτή η σύγκριση εξηγεί γιατί η λάθος αυτοθεραπεία είναι τόσο συχνή. Η γυναίκα μπορεί να νομίζει ότι έχει μύκητες και να βάζει αντιμυκητιασικά, ενώ στην πραγματικότητα έχει BV. Ή το αντίστροφο. Για αυτό η σωστή εργαστηριακή και κλινική προσέγγιση έχει πολύ μεγαλύτερη αξία από την εμπειρική δοκιμή σκευασμάτων.
13
Τι μπορεί να αλλοιώσει το αποτέλεσμα της καλλιέργειας
Η αξιοπιστία της κολπικής καλλιέργειας μπορεί να επηρεαστεί από διάφορους παράγοντες. Οι πιο συχνοί είναι η πρόσφατη χρήση αντιβιοτικών, αντιμυκητιασικών, κολπικών ωαρίων, κολπικών πλύσεων, τοπικών αντισηπτικών ή άλλων ενδοκολπικών προϊόντων. Όλα αυτά μπορούν να αλλάξουν προσωρινά τη σύνθεση του μικροβιώματος ή να μειώσουν την ανίχνευση ορισμένων μικροβίων.
Η σεξουαλική επαφή πολύ κοντά στον χρόνο της λήψης, η έντονη έμμηνος ρύση, ακόμη και ορισμένες πρακτικές προσωπικής υγιεινής μπορούν επίσης να επηρεάσουν την εικόνα. Για αυτόν τον λόγο, πριν από τη λήψη είναι σημαντικό να ακολουθούνται οι οδηγίες του γιατρού ή του εργαστηρίου και να αναφέρεται κάθε πρόσφατη χρήση φαρμάκων ή σκευασμάτων.
Η ασθενής συχνά πιστεύει ότι αν έβαλε μόνο ένα ωάριο ή μία κρέμα «δεν πειράζει». Στην πραγματικότητα, ακόμη και αυτή η μικρή παρέμβαση μπορεί να θολώσει την εικόνα. Το ίδιο ισχύει και για τις κολπικές πλύσεις, οι οποίες όχι μόνο μπορούν να αλλοιώσουν το αποτέλεσμα, αλλά γενικά δεν αποτελούν καλή πρακτική για τη φυσιολογική κολπική ισορροπία.
Επομένως, όταν ένα αποτέλεσμα δεν ταιριάζει με τα συμπτώματα, δεν σημαίνει πάντα ότι το εργαστήριο έκανε λάθος. Μπορεί απλώς να έχει προηγηθεί κάτι που τροποποίησε τη βιολογική πραγματικότητα του δείγματος.
14
Γιατί η Gardnerella υποτροπιάζει τόσο συχνά
Η υποτροπή είναι ένα από τα πιο απογοητευτικά χαρακτηριστικά της βακτηριακής κολπίτιδας. Πολλές γυναίκες νιώθουν ότι «θεραπεύτηκαν» και μετά από μερικές εβδομάδες ή μήνες η οσμή και τα υγρά επανέρχονται. Αυτό δεν σημαίνει απαραίτητα λάθος θεραπεία, αλλά συχνά δείχνει ότι η βασική ισορροπία της χλωρίδας δεν αποκαταστάθηκε σταθερά.
Το Gardnerella συμμετέχει σε βιοφίλμ, μια μικροβιακή δομή που το βοηθά να επιμένει στο επιθήλιο. Αυτό κάνει πιο εύκολη την επανεμφάνιση της δυσβίωσης. Παράλληλα, αν οι λακτοβάκιλλοι δεν επανέλθουν επαρκώς, το περιβάλλον παραμένει ευάλωτο στην επανάληψη του ίδιου προβλήματος.
Παράγοντες που μπορεί να ευνοούν υποτροπές είναι οι κολπικές πλύσεις, η συχνή και άσκοπη χρήση τοπικών σκευασμάτων, οι επαναλαμβανόμενες αντιβιώσεις, η αλλαγή pH μετά από διάφορες συνθήκες, αλλά και ορισμένα μοτίβα που σχετίζονται με το σεξουαλικό ή καθημερινό ιστορικό. Αυτό δεν σημαίνει ότι υπάρχει ένα μόνο «φταίξιμο», αλλά ότι η υποτροπή είναι πολυπαραγοντικό φαινόμενο.
Σε γυναίκες με συχνές υποτροπές, η αντιμετώπιση πρέπει να είναι πιο οργανωμένη. Χρειάζεται επιβεβαίωση ότι πρόκειται πράγματι για BV, αποκλεισμός μικτής λοίμωξης, σωστή ερμηνεία των αποτελεσμάτων και ενίοτε διαφορετική στρατηγική παρακολούθησης από αυτήν που θα εφαρμοζόταν σε ένα απλό, μεμονωμένο επεισόδιο.
15
Πότε χρειάζεται θεραπεία
Η θεραπεία στηρίζεται κυρίως στο αν η γυναίκα είναι συμπτωματική. Όταν υπάρχουν δύσοσμα υγρά, χαρακτηριστική ψαρίλα, ενόχληση ή σαφής εικόνα βακτηριακής κολπίτιδας, η θεραπεία έχει ουσιαστικό κλινικό όφελος. Ανακουφίζει τα συμπτώματα, βελτιώνει την ποιότητα ζωής και βοηθά να αποκατασταθεί η κολπική ισορροπία.
Αντίθετα, όταν η γυναίκα δεν έχει συμπτώματα, η απόφαση δεν είναι πάντα αυτονόητη. Η απλή λέξη Gardnerella στην καλλιέργεια δεν οδηγεί υποχρεωτικά σε φαρμακευτική αγωγή. Εκεί λαμβάνονται υπόψη το ιστορικό, η κύηση, οι υποτροπές, τυχόν παρεμβάσεις που επίκεινται και η συνολική ιατρική εκτίμηση.
Στην καθημερινή πράξη χρησιμοποιούνται συνήθως σχήματα με μετρονιδαζόλη ή κλινδαμυκίνη, από του στόματος ή τοπικά, ανάλογα με το περιστατικό. Η επιλογή σχήματος εξαρτάται από πολλούς παράγοντες, όπως προηγούμενη αποτυχία, δυσανεξία, εγκυμοσύνη, μικτή εικόνα και συχνότητα υποτροπών. Για αυτό η θεραπεία δεν πρέπει να γίνεται με αυτοσχεδιασμό.
Το σωστό ερώτημα δεν είναι «βρέθηκε μικρόβιο, να πάρω κάτι;». Το σωστό ερώτημα είναι «υπάρχει κλινικά σημαντική εικόνα που χρειάζεται θεραπεία;». Εκεί βρίσκεται όλη η ουσία.
16
Εγκυμοσύνη και Gardnerella στην κολπική καλλιέργεια
Στην εγκυμοσύνη, το θέμα γίνεται πιο ευαίσθητο. Η συμπτωματική βακτηριακή κολπίτιδα έχει συσχετιστεί με αυξημένο κίνδυνο για ορισμένες επιπλοκές, όπως πρόωρη ρήξη υμένων και πρόωρο τοκετό. Για αυτό, όταν μια έγκυος εμφανίζει δύσοσμα υγρά ή άλλη συμβατή συμπτωματολογία και η διερεύνηση αναφέρει Gardnerella ή εικόνα BV, η κατάσταση πρέπει να αξιολογηθεί σοβαρά.
Από την άλλη πλευρά, η τυχαία ανεύρεση Gardnerella σε ασυμπτωματική έγκυο δεν σημαίνει ότι όλες οι γυναίκες χρειάζονται την ίδια αντιμετώπιση ή ότι πρέπει να ξεκινήσουν άμεσα φάρμακα από μόνες τους. Η απόφαση είναι ιατρική και εξατομικευμένη. Βασίζεται στο συνολικό μαιευτικό ιστορικό, στο τρίμηνο, στην ύπαρξη συμπτωμάτων, στο αν υπάρχουν παλιότερες επιπλοκές και στη γνώμη του γυναικολόγου.
Η έγκυος γυναίκα πρέπει να αποφεύγει πλήρως την αυτοθεραπεία, είτε πρόκειται για αντιβίωση είτε για τοπικά σκευάσματα. Οποιοδήποτε αποτέλεσμα που αναφέρει Gardnerella ή βακτηριακή κολπίτιδα πρέπει να συζητείται με τον θεράποντα ιατρό της κύησης.
Το ουσιαστικό μήνυμα είναι το εξής: στην εγκυμοσύνη, η παρουσία συμβατών συμπτωμάτων και η σωστή ερμηνεία της εξέτασης έχουν μεγαλύτερη σημασία από τον φόβο που προκαλεί μια λέξη στο χαρτί. Η διαχείριση πρέπει να είναι ψύχραιμη, αλλά όχι αδιάφορη.
17
Χρειάζεται θεραπεία και ο σύντροφος;
Αυτό είναι από τα πιο συχνά ερωτήματα που ακολουθούν ένα θετικό αποτέλεσμα. Πολλές γυναίκες αναρωτιούνται αν πρέπει να πάρει θεραπεία και ο σύντροφος, ειδικά όταν υπάρχουν υποτροπές. Η κλασική προσέγγιση στις κατευθυντήριες οδηγίες δεν ήταν να θεραπεύεται rutinely κάθε σύντροφος σε κάθε επεισόδιο BV, επειδή η βακτηριακή κολπίτιδα δεν αντιμετωπίζεται με τον ίδιο τρόπο όπως ένα τυπικό ΣΜΝ.
Παρόλα αυτά, η συζήτηση έχει εξελιχθεί τα τελευταία χρόνια, κυρίως στις περιπτώσεις με πολλές υποτροπές. Αυτό σημαίνει ότι το ζήτημα δεν πρέπει να απαντάται με απόλυτα απλοϊκό τρόπο. Δεν ισχύει γενικά το «πάντα ναι» ούτε το «πάντα όχι». Ισχύει περισσότερο το «εξαρτάται από το ιστορικό και από το πώς αξιολογεί ο γιατρός το μοτίβο των υποτροπών».
Για την καθημερινή πράξη, η γυναίκα δεν πρέπει να ξεκινά αυτόματα φάρμακα για τον σύντροφό της ούτε να υποθέτει ότι το πρόβλημα σημαίνει οπωσδήποτε «μετάδοση» με την απλουστευμένη έννοια. Στα απλά επεισόδια, συνήθως η συζήτηση εστιάζει περισσότερο στην ίδια τη γυναίκα, στη χλωρίδα και στην ερμηνεία της κλινικής εικόνας. Σε πιο σύνθετα περιστατικά, ο γυναικολόγος μπορεί να κρίνει αν χρειάζεται άλλη στρατηγική.
18
Πρακτική προετοιμασία πριν από την κολπική καλλιέργεια
Η σωστή προετοιμασία πριν από την κολπική καλλιέργεια είναι ιδιαίτερα σημαντική, γιατί ένα δείγμα που λαμβάνεται σε ακατάλληλες συνθήκες μπορεί να οδηγήσει σε λιγότερο χρήσιμο ή παραπλανητικό αποτέλεσμα. Γενικά, πριν από τη λήψη καλό είναι να αποφεύγονται οι κολπικές πλύσεις, τα ενδοκολπικά αντισηπτικά, τα ωάρια και οι τοπικές κρέμες, εκτός αν υπάρχει διαφορετική σαφής οδηγία από τον γιατρό.
Συχνά συστήνεται επίσης αποχή από σεξουαλική επαφή λίγο πριν από την εξέταση, καθώς και αποφυγή λήψης σε χρονική στιγμή με έντονη αιμορραγία, όταν αυτό δεν είναι ιατρικά αναγκαίο. Εάν η γυναίκα έχει ήδη λάβει αντιβίωση, έχει χρησιμοποιήσει αντιμυκητιασικά ή έχει δοκιμάσει διάφορα σκευάσματα από μόνη της, πρέπει να το αναφέρει πάντοτε. Αυτή η πληροφορία μπορεί να εξηγήσει πολλά στην ερμηνεία του αποτελέσματος.
| Τι να αποφύγετε πριν από τη λήψη | Γιατί έχει σημασία |
|---|---|
| Κολπικές πλύσεις / ενδοκολπικά «καθαριστικά» | Αλλάζουν το pH και τη χλωρίδα |
| Ωάρια, κρέμες, αντισηπτικά χωρίς οδηγία | Μπορούν να κρύψουν ή να αλλοιώσουν την πραγματική εικόνα |
| Πρόσφατη αντιβίωση | Μπορεί να τροποποιήσει την ανάπτυξη των μικροβίων στο δείγμα |
| Σεξουαλική επαφή αμέσως πριν την εξέταση | Μπορεί να μεταβάλει την εικόνα των εκκρίσεων και του pH |
Η σωστή λήψη είναι ουσιαστικό κομμάτι της αξιοπιστίας της εξέτασης. Συχνά η γυναίκα εστιάζει μόνο στο «τι έβγαλε» το αποτέλεσμα, αλλά εξίσου σημαντικό είναι πώς ελήφθη και σε ποιο βιολογικό περιβάλλον.
19
Συχνά λάθη στην ερμηνεία και στην αυτοθεραπεία
Το πιο συχνό λάθος είναι να αντιμετωπίζονται όλα τα κολπικά ενοχλήματα σαν «μύκητες». Το δεύτερο είναι να θεωρείται ότι κάθε θετική αναφορά σε Gardnerella σημαίνει αυτόματα σοβαρή λοίμωξη ή «κόλλησα κάτι». Το τρίτο είναι να αγνοείται το γεγονός ότι η βακτηριακή κολπίτιδα είναι κυρίως δυσβίωση και όχι απλή απομόνωση ενός παθογόνου.
Πολλές γυναίκες δοκιμάζουν μόνες τους αντιμυκητιασικά, κολπικά αντισηπτικά ή διάφορα σκευάσματα επειδή είδαν κάποια υγρά ή αισθάνθηκαν ενόχληση. Αυτό μπορεί να καθυστερήσει τη σωστή διάγνωση και να αλλοιώσει την εικόνα της εξέτασης. Επίσης, η άσκοπη χρήση αντιβιοτικών ή τοπικών προϊόντων μπορεί να χειροτερέψει τη διαταραχή της χλωρίδας.
Άλλο λάθος είναι ο πανικός με λέξεις όπως «Gardnerella» ή «αιμόφιλος». Οι λέξεις έχουν σημασία, αλλά δεν είναι το ίδιο σημαντικές με τη σωστή κλινική ερμηνεία. Το αποτέλεσμα δεν διαβάζεται σαν τίτλος εφημερίδας. Διαβάζεται σαν ιατρικό δεδομένο που πρέπει να μπει στο σωστό πλαίσιο.
Τέλος, συχνό λάθος είναι να αγνοούνται οι υποτροπές και να επαναλαμβάνεται η ίδια τυφλή αντιμετώπιση ξανά και ξανά. Όταν το πρόβλημα επανέρχεται, χρειάζεται επανεκτίμηση και όχι απλώς επανάληψη της προηγούμενης αγωγής χωρίς επανέλεγχο.
Να αντιμετωπίζεται η φράση «Gardnerella vaginalis στην κολπική καλλιέργεια» σαν τελική διάγνωση από μόνη της, χωρίς συσχέτιση με συμπτώματα, pH, μικροσκόπηση και γυναικολογική εικόνα.
20
Συχνές ερωτήσεις
Αν βγει Gardnerella στην κολπική καλλιέργεια έχω σίγουρα βακτηριακή κολπίτιδα;
Όχι απαραίτητα. Το εύρημα χρειάζεται συσχέτιση με τα συμπτώματα, το pH, τη μικροσκόπηση και τη συνολική κλινική εικόνα.
Το Gardnerella είναι σεξουαλικώς μεταδιδόμενο νόσημα;
Όχι με τον κλασικό τρόπο που μιλάμε για ένα τυπικό ΣΜΝ. Συνδέεται με σεξουαλικούς παράγοντες, αλλά κυρίως εκφράζει διαταραχή της κολπικής χλωρίδας.
Το «αιμόφιλος» είναι άλλο μικρόβιο από το Gardnerella;
Συχνά όχι. Σε παλαιότερη ορολογία, ο όρος Haemophilus vaginalis σχετίζεται ιστορικά με το Gardnerella vaginalis.
Η κολπική καλλιέργεια είναι το καλύτερο τεστ για βακτηριακή κολπίτιδα;
Όχι πάντα. Η βακτηριακή κολπίτιδα αξιολογείται συχνά καλύτερα με συνδυασμό κλινικών κριτηρίων, pH, μικροσκόπησης και όπου χρειάζεται νεότερων μεθόδων.
Αν δεν έχω συμπτώματα, πρέπει πάντα να θεραπευτώ;
Όχι πάντα. Η απόφαση εξαρτάται από το ιστορικό, την εγκυμοσύνη, τις υποτροπές και τη γνώμη του θεράποντος ιατρού.
Μπορεί η βακτηριακή κολπίτιδα να υποτροπιάζει συχνά;
Ναι. Οι υποτροπές είναι συχνές γιατί το πρόβλημα αφορά διαταραχή της χλωρίδας και συχνά σχετίζεται με επιμονή βιοφίλμ.
Μπορώ να βάλω μόνη μου αντιμυκητιασικό μέχρι να δω γιατρό;
Δεν είναι καλή ιδέα όταν δεν έχει ξεκαθαριστεί η αιτία, γιατί μπορεί να αλλοιωθεί η εικόνα και να καθυστερήσει η σωστή διάγνωση.
Στην εγκυμοσύνη χρειάζεται περισσότερη προσοχή;
Ναι, ιδιαίτερα όταν υπάρχουν συμπτώματα, γιατί η συμπτωματική βακτηριακή κολπίτιδα έχει συσχετιστεί με αυξημένο κίνδυνο για ορισμένες επιπλοκές της κύησης.
21
Τι να θυμάστε
Κύρια σημεία:
Το Gardnerella vaginalis στην κολπική καλλιέργεια δεν σημαίνει πάντοτε από μόνο του ενεργή, σοβαρή λοίμωξη. Πολύ συχνά σχετίζεται με βακτηριακή κολπίτιδα, δηλαδή με διαταραχή της φυσιολογικής χλωρίδας.
Ο όρος «αιμόφιλος» μπορεί να είναι παλαιότερη ή ιστορική αναφορά που σχετίζεται με το Gardnerella vaginalis και δεν πρέπει να προκαλεί αυτόματα πανικό.
Η σωστή ερμηνεία δεν βασίζεται μόνο στο αποτέλεσμα της καλλιέργειας, αλλά σε συμπτώματα, pH, μικροσκόπηση, ιστορικό και γυναικολογική εκτίμηση.
Η θεραπεία συνήθως αφορά κυρίως τις συμπτωματικές γυναίκες και πρέπει να καθορίζεται από γιατρό, ιδίως όταν υπάρχει εγκυμοσύνη, συχνή υποτροπή ή μικτή κλινική εικόνα.
22
Κλείστε Ραντεβού & Βιβλιογραφία
Ερμηνεία αποτελεσμάτων από ιατρό στο εργαστήριό μας. Μπορείτε να προγραμματίσετε εξέταση ή να δείτε τον πλήρη κατάλογο διαθέσιμων εξετάσεων.
https://www.cdc.gov/std/treatment-guidelines/bv.htm
https://mikrobiologikolamia.gr/katalogos-eksetaseon/
Δρ. Παντελής Αναγνωστόπουλος, Ιατρός Μικροβιολόγος – Βιοπαθολόγος
Μικροβιολογικό Εργαστήριο Λαμίας, Έσλιν 19, Λαμία 35100
📞 +30-22310-66841 • Δευτέρα–Παρασκευή 07:00–13:30
Δρ. Παντελής Αναγνωστόπουλος
Ιατρός Μικροβιολόγος – Βιοπαθολόγος, επιστημονικά υπεύθυνος στο Μικροβιολογικό Λαμία.
